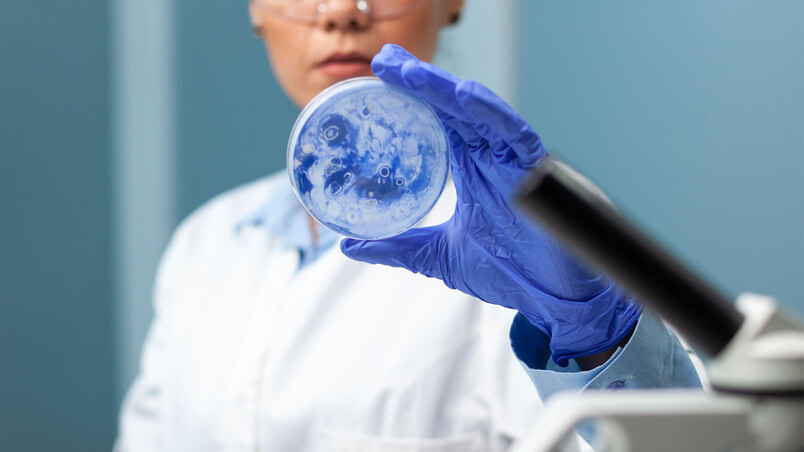

Congélateur de laboratoire
Stockage à basse température

Caractéristiques
Réf.: iLF | HLF
Uniformité maximale de la température et récupération rapide
Contrôle de la température
-30 °C
Température réglée
-15 à -30 °C
Plage de température
tiroirs, étagères et paniers coulissants
Options de stockage personnalisées

Congélateurs de laboratoire
Les congélateurs de laboratoire assurent le stockage à basse température des préparations sensibles aux variations de température dans des conditions optimales, grâce à plus de 40 ans d’expérience.
Tailles des modèles – série i
| Modèle | Capacité | Nb. d'étagères | Porte(s) | Dimensions ext. (LxHxP) | Poids net |
|---|---|---|---|---|---|
| iLF105-GX | 150 l | 2 | 1 - Plein | 610 x 798 x 678 mm | 82 kg |
| iLF120-GX | 572 l | 4 | 1 - Plein | 737 x 2039 x 726 mm | 182 kg |
| iLF125-GX | 714 l | 4 | 1 - Plein | 737 x 2039 x 878 mm | 202 kg |
Model sizes - Horizon Series
| Modèle | Capacité | Nb. d'étagères | Porte(s) | Dimensions ext. (LxHxP) | Poids net |
|---|---|---|---|---|---|
| HLF105-GX | 150 l | 2 | 1 - Plein | 610 x 798 x 678 mm | 82 kg |
| HLF120-GX | 572 l | 4 | 1 - Plein | 737 x 2039 x 726 mm | 181 kg |
| HLF125-GX | 714 l | 4 | 1 - Plein | 737 x 2039 x 878 mm | 201 kg |
Domaines d'application

- Laboratoire clinique
- Pharmacie
- Soins intensifs
- Nursing
- BioMed

- Département de la santé
- Clinique
- Cabinet médical
- Université
Les accessoires appropriés pour ce produit
Vos accessoires parfaits !
Nous proposons une large gamme d'accessoires pour votre appareil Helmer.
Contactez-nous et nous serons ravis de vous aider à choisir les accessoires appropriés.

Comment pouvons-nous vous aider?
Veuillez nous faire part de votre demande afin de trouver votre interlocuteur personnel.
